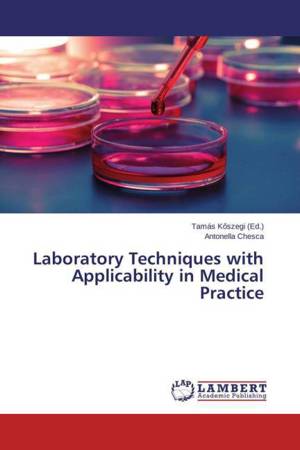

- Retrait en 2 heures
- Assortiment impressionnant
- Paiement sécurisé
- Toujours un magasin près de chez vous
- Retrait gratuit dans votre magasin Club
- 7.000.0000 titres dans notre catalogue
- Payer en toute sécurité
- Toujours un magasin près de chez vous
Résultats pour "Antonella Chesca"
-
Clinical Laboratory
Antonella Chesca, Tim Sandle
- Livre broché | Anglais
- Medical laboratory, as a field of activity involves teamwork. The specialization of Laboratory Medicine is achieved by studying the following medical ... Savoir plus
58,45 €Livraison 2 à 3 semaines58,45 €Livraison 2 à 3 semaines -
Techniques and Procedures for Diseases Diagnostic
Antonella Chesca
- Livre broché | Anglais
- The book interweaves theoretical and practical informations about techniques and procedures used for diseases diagnostic. Is a collaborative book, aft... Savoir plus
45,95 €Livraison sous 1 à 4 semaines45,95 €Livraison sous 1 à 4 semaines -
Tissu Épithélial
Antonella Chesca, Tim Sandle, Galiya Abdulina
- Livre broché | Français
- L'histologie fait référence à l'étude des tissus normaux.Le tissu représente un groupe de cellules ayant les mêmes caractéristiques et des rôles commu... Savoir plus
47,95 €Livraison sous 1 à 4 semaines47,95 €Livraison sous 1 à 4 semaines -
Theory and practice for diseases diagnosis
Antonella Chesca, Mujgan Cengiz, Tim Sandle
- Livre broché | Anglais
- The book provides theoretical and practical informations for diseases diagnosis. It is a collaborative book after IP Erasmus project MDHP, with partne... Savoir plus
49,45 €Livraison sous 1 à 4 semaines49,45 €Livraison sous 1 à 4 semaines -
Theory and Practice for Medical Diagnosis
Antonella Chesca, Mujgan Cengiz
- Livre broché | Anglais
- With this volume, we complete a successful international collaboration with collaborators from IP Erasmus project entitled "Classic and Modern Methods... Savoir plus
41,45 €Livraison sous 1 à 4 semaines41,45 €Livraison sous 1 à 4 semaines -
Laboratory Techniques with Applicability in Medical Practice
Antonella Chesca
- Livre broché | Anglais
- The book is recommended to young researchers in experimental medicine. The topics cover a wide range of state of the art methods: microbiological tech... Savoir plus
44,95 €Livraison sous 1 à 4 semaines44,95 €Livraison sous 1 à 4 semaines -
Methods for Diseases Diagnostic with Applicability in Practice
Antonella Chesca
- Livre broché | Anglais
- The book interweaves theoretical and practical informations for diseases diagnostic. Is a collaborative book after IP Erasmus project MDHP, with partn... Savoir plus
49,95 €Livraison sous 1 à 4 semaines49,95 €Livraison sous 1 à 4 semaines
7 sur 7 résultat(s) affiché(s)